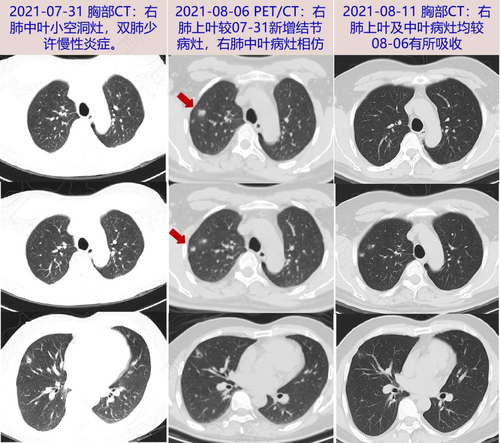
肺结核胸痛是哪里痛 肺结核胸痛是哪里痛

肺结核属于较为常见的肺部疾病,这需要尽快治疗,否则对健康有很大的损害。由于肺结核是传染性疾病,所以患者在进行治疗期间,还必须要做好防护,以免将肺结核传染给家属。那么,肺结核胸痛是什么部位呢?
在患了肺结核时,通常都会出现胸痛的症状,患者疼痛的位置在胸骨左下缘,一般在患者呼吸时,疼痛感会较为明显。患了肺结核时出现的胸痛症状,可能是由于肺结核疾病引起了胸膜炎造成的,而且在引发气胸时,也会有胸痛症状,但是部位并不确定。
在患了肺结核之后,便会出现很多的症状,除了胸部疼痛之外,还会出现发热的情况,大多都表现为低热。另外,肺结核患者一般还有盗汗、乏力以及消瘦等症状。而女性在患病之后,还会出现月经失调的情况。
肺部属于呼吸器官,因此患上了肺结核以后,还会出现呼吸系统的异常症状,例如胸闷、咳嗽、咳痰等,在严重的时候,还出出现咯血以及呼吸困难的症状。如果大家由以上症状,便应该予以重视,这很可能是患了肺结核,因此需要立即就医检查。
标签:
